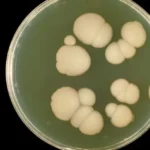

Колибри видят мир в недоступных человеку цветах
Исследование, проведенное на цветущих лугах Колорадо, подтверждает нам, что колибри воспринимают комбинации цветов, недоступных человеческому глазу.
В отличие от людей, у которых есть три типа чувствительных к цвету колбочек в глазах — при красном, зеленом и синем свете — птицы имеют четвертый тип, чувствительный к ультрафиолетовому свету. Таким образом, они очень хорошо видят цвета.
«Четвертый тип колбочек не только расширяет цветовую гамму, видимую птицам в ультрафиолетовом свете, но и потенциально позволяет птицам воспринимать комбинированные цвета. Как «ультрафиолетовый + зеленый» и «ультрафиолетовый + красный», — объясняет Мэри Кэсвелл Стоддард с факультета экологии и эволюционной биологии Принстонского университета (США).
В конце концов, «люди кажутся настоящими дальтониками по сравнению с птицами», добавляет исследователь.
Тем не менее изучение того, как птицы воспринимают мир, является сложным делом. Как правило, такие эксперименты проводятся в лаборатории, но, как отмечает биолог, ничто не сравнится с полевым исследованием.
Чтобы исследовать цветовое видение птиц в естественной обстановке, Мэри Касвелл Стоддард и ее команда отправились в Колорадо, чтобы сосредоточиться на диких широкохвостых колибри ( Selasphorus platycercus ).
Эти птицы эволюционировали в соответствии с цветами цветов, которые предлагают им сладкий нектар, поэтому они представляли себя идеальными предметами изучения.

Не спектральные цвета
В рамках этой работы исследователи проявили особый интерес к «неспектральным» цветовым сочетаниям. Они включают в себя оттенки из широко разделенных частей цветового спектра, в отличие от смесей соседних цветов, таких как зелено-красный (который дает желтый).
Для людей фиолетовый является ярким примером так называемого «не спектрального» цвета. Это кажется нам, когда стимулируются наши синие колбочки (короткие волны) и красные колбочки (длинные волны), но не зеленые колбочки (средние волны).
При этом, в то время как мы, бедные люди, можем воспринимать только один, не спектральный цвет (фиолетовый, следовательно), птицы теоретически могут видеть до пяти: фиолетовый, ультрафиолетовый + красный, ультрафиолетовый + зеленый, ультрафиолетовый + желтый и ультрафиолетовый + фиолетовый.
В прериях Колорадо
Для проверки этой теории исследователи каждое лето в течение трех лет проводили несколько экспериментов на альпийском лугу, часто посещаемом этими колибри, которые прилетают сюда для размножения.
Каждое утро исследователи вставали перед рассветом и устанавливали две кормушки: одна содержала сладкую воду, а другая-простую воду. Рядом с каждой кормушкой они затем размещали светодиодную трубку, запрограммированную на отображение нескольких не спектральных цветов.
Трубка рядом со сладкой водой излучала один цвет, а трубка рядом с обычной водой излучала другой. Исследователи периодически меняли местами поощрительных и не поощрительные трубки, поэтому птицы не могли просто использовать это место, чтобы найти сладкое угощение.
Они также проводили контрольные эксперименты, чтобы убедиться, что птицы не использовали запах или другой непреднамеренный сигнал, чтобы найти награду. Таким образом, идея заключалась в том, что они учатся ассоциировать тот или иной цвет с лакомством (сладкой водой). Что колибри и сделали всего за несколько часов.

Красочный мир
Затем эти эксперименты показали, что эти птицы действительно могут видеть различные не спектральные цвета, включая фиолетовый, ультрафиолетовый + зеленый, ультрафиолетовый + красный и ультрафиолетовый + желтый.
Например, исследователи отмечают, что им удалось отличить ультрафиолетовый + зеленый от чистого ультрафиолетового или чистого зеленого. Еще лучше, что они могли бы также различить ультрафиолет, связанный с красным, и ультрафиолет, связанный с менее выраженным красным.
«Было удивительно наблюдать, — сказал Гарольд Эйстер, соавтор исследования. Ультрафиолетовый + зеленый свет и зеленый свет показались нам одинаковыми, но колибри продолжали правильно выбирать ультрафиолетовый + зеленый свет в сочетании со сладкой водой. Наш опыт позволил нам получить представление о том, как выглядит мир для Колибри».
Конечно, нам очень трудно, если не невозможно, представить, что на самом деле видят эти птицы. Например, является ли ультрафиолет + красный смесью этих цветов или совершенно новым цветом? Мы можем только строить догадки.
Источник